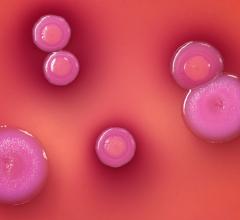
SNMMI Radioluminescence Single Cells Nuclear Imaging

RELATED CONTENT
With a new molecular imaging system powerful enough to peer down to 20-micrometer resolution, researchers can now use radioluminescence to examine the characteristics of single, unconnected cells. The result is a fascinating picture of diversity among cells previously assumed to behave the same, revealed researchers at the Society of Nuclear Medicine and Molecular Imaging’s 2014 Annual Meeting (SNMMI).
Taking their pick, biomedical researchers can now conduct five different imaging studies in one scan with a state-of-the-art preclinical molecular imaging system that scientists unveiled during the Society of Nuclear Medicine and Molecular Imaging’s 2014 Annual Meeting.
The Society of Nuclear Medicine and Molecular Imaging (SNMMI) announced that the U.S. Food and Drug Administration (FDA) has designated the radiopharmaceutical Gallium-68 (DOTA0-Phel-Tyr3) octreotide (Ga-68 DOTATOC) as an orphan drug for the management of neuroendocrine tumors (NET).
To recognize the advances in the field of nuclear and molecular imaging, as well as the professionals who carry out these procedures, the Society of Nuclear Medicine and Molecular Imaging (SNMMI) and the SNMMI Technologist Section (SNMMI-TS) celebrated Nuclear Medicine and Molecular Imaging Week, October 6-12, 2013. The theme of this year’s Nuclear Medicine and Molecular Imaging Week was “Molecular Imaging: The Future…Delivered.”
To recognize the advances in the field of nuclear and molecular imaging, as well as the professionals who carry out these procedures, the Society of Nuclear Medicine and Molecular Imaging (SNMMI) and the SNMMI Technologist Section (SNMMI-TS) celebrate Nuclear Medicine and Molecular Imaging Week, Oct. 6-12, 2013. The theme of this year’s Nuclear Medicine and Molecular Imaging Week is “Molecular Imaging: The Future … Delivered.”
The Society of Nuclear Medicine and Molecular Imaging (SNMMI) is disappointed in the draft Medicare decision from the Centers for Medicare & Medicaid Services (CMS) proposing Coverage with Evidence Development for the use of beta-amyloid positron emission tomography (PET) imaging agents. SNMMI believes that sufficient evidence exists to support immediate coverage, which would change patient management, leading to better health outcomes for patients and assisting families making care decisions.
When prostate cancer makes a comeback, it becomes increasingly important to have exceptional imaging available to find all possible regions where cancer has spread to other parts of the body, or metastasized, in order to plan the best possible treatment. A relatively new imaging system that simultaneously combines positron emission tomography and magnetic resonance (PET/MR) demonstrates a higher capacity for mapping recurrent prostate cancer than the already high standard of integrated PET and computed tomography (PET/CT), say researchers presenting a study at the Society of Nuclear Medicine and Molecular Imaging’s 2013 Annual Meeting.
One of the biggest hurdles of hybrid positron emission tomography and magnetic resonance (PET/MR) imaging is the prevalence of motion artifacts—blurring and ghostly visual anomalies caused by patient motion on the table during imaging. An MR technology has now been designed for PET/MR that employs tiny radiofrequency solenoids—metal coils integrated into hardware placed on the body—to track motion from those who do not or cannot stay put. Special software can then use the additional information provided by the coils to optimize the image, according to research being revealed at SNMMI’s 2013 Annual Meeting.
The Society of Nuclear Medicine and Molecular Imaging’s 2013 Annual Meeting marks the unveiling of the successful application of a new preclinical hybrid molecular imaging system—single photon emission tomography and magnetic resonance (SPECT/MR)—which has exceptional molecular imaging capabilities in terms of potential preclinical and clinical applications, technological advancement at a lower cost, and reduction of patient exposure to ionizing radiation.
For patients with advanced breast cancer, positron emission tomography (PET) and magnetic resonance (MR) imaging can improve quality of life and survival by providing physicians with information on the effectiveness of chemotherapy prior to surgery, say researchers presenting at the 2013 Annual Meeting of the Society of Nuclear Medicine and Molecular Imaging.

June 11, 2014
June 11, 2014 



